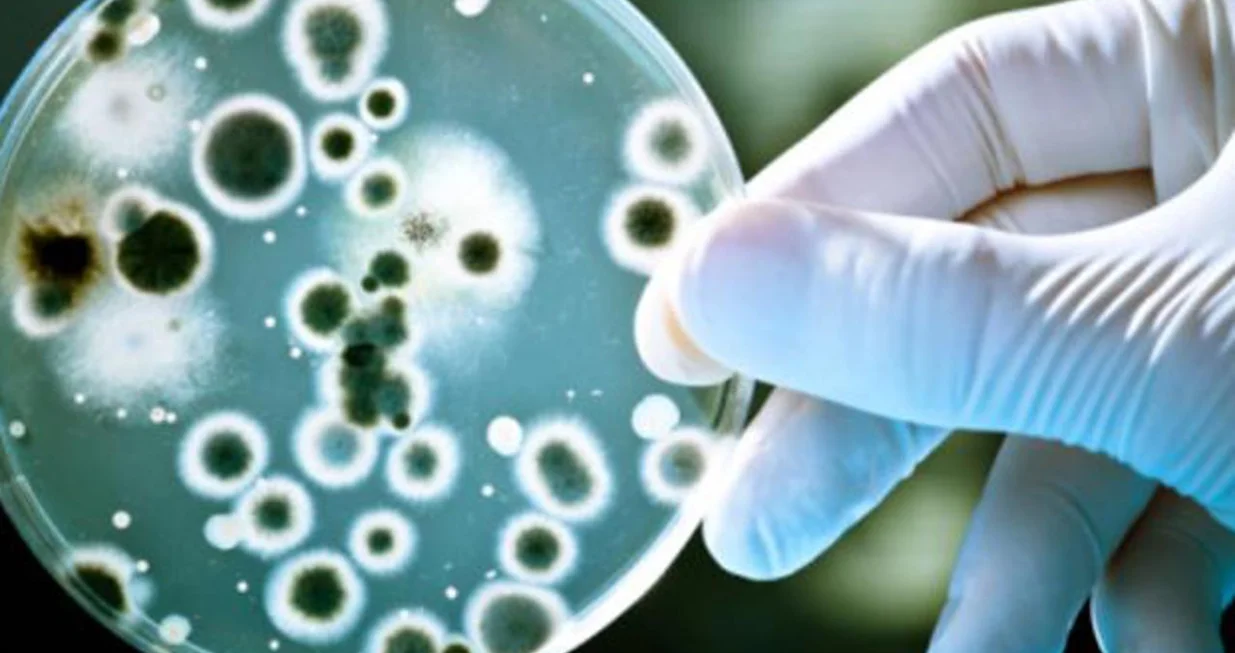
bakterija, plastika/

Šok u naučnom svijetu: Deset godina rješavali problem, AI ga riješio za samo dva dana!
Složeni problem na kojem su mikrobiolozi radili deset godina riješen je u samo 48 sati zahvaljujući novom alatu umjetne inteligencije (AI).
Profesor José R. Penadés i njegov tim s Imperial College London godinama su istraživali i dokazivali kako određene superbakterije postaju otporne na antibiotike.
Kada je svom „su-naučniku“ – alatu koji je razvio Google – dao kratak upit u vezi s problemom na kojem je radio, AI je došao do istog zaključka za samo dva dana.
Za BBC je ispričao koliko ga je to šokiralo, s obzirom na to da njegovo istraživanje još nije bilo objavljeno, pa AI nije mogao doći do tih informacija putem javno dostupnih izvora.
- Bio sam u kupovini s nekim i rekao sam mu: "Molim te, ostavi me sat vremena na miru, moram ovo da procesuiram", kazao je u programu Today na BBC Radio Four.
Nakon toga je poslao e-mail Googleu s pitanjem: "Imate li pristup mom računaru?"
Tehnološki gigant mu je odgovorio da nema.
Deset godina rada naučnika uključivalo je i godine potrebne za dokazivanje njihovog istraživanja. No, da su od početka imali ovu hipotezu, mogli su uštedjeti godine rada.
AI generiše i nove ideje
Profesor Penadés ističe da AI nije samo potvrdio njihovu hipotezu, već je ponudio i dodatne prijedloge.
- Nije samo dao tačan odgovor kao prvu opciju, rekao je.
- Dao je još četiri hipoteze i sve su imale smisla. Jedna od njih nam nikada nije pala na pamet i sada radimo na tome.
Istraživači pokušavaju otkriti kako nastaju superbakterije – opasni mikroorganizmi otporni na antibiotike.
Njihova hipoteza je da se superbakterije mogu koristiti repovima različitih virusa kako bi se širile među vrstama.
Profesor Penadés ovu pojavu poredi s „ključevima“ koji superbakterijama omogućavaju da se premještaju s jednog domaćina na drugog.
Ova hipoteza bila je jedinstvena za njegov istraživački tim i nigdje nije bila objavljena niti podijeljena. Zato su je smatrali idealnim testom za novi AI alat.
Samo dva dana kasnije, AI je iznio nekoliko hipoteza – a njegova prva ideja, vodeći prijedlog, u potpunosti se podudarao s opisom iz njihovog istraživanja.
AI će promijeniti nauku
Uloga AI-ja u nauci izaziva podijeljene reakcije. Dok jedni tvrde da će omogućiti veliki napredak, drugi se boje da će dovesti do gubitka radnih mjesta.
Profesor Penadés razumije ove strahove, ali smatra da se AI treba posmatrati kao „izuzetno moćan alat“ koji će unaprijediti istraživanja.
- Osjećam da će ovo definitivno promijeniti nauku, rekao je.
- Imam osjećaj da igram veliku utakmicu – kao da sam konačno u Ligi prvaka s ovim alatom.



















